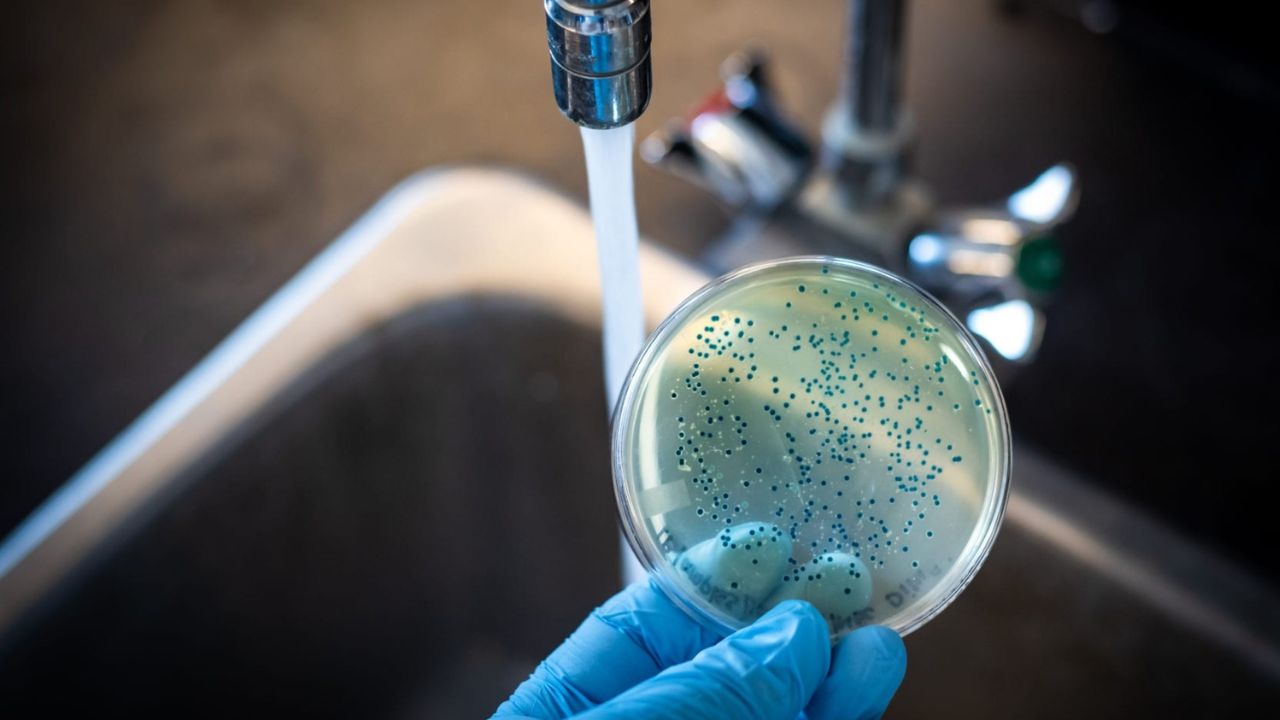
khu-clo-trong-nuoc-1

Nước Clo là một trong những nguồn nước quan trọng mà chúng ta sử dụng hàng ngày. Tuy nhiên, việc sử dụng Clo cũng có thể gây ra mùi hôi khó chịu và tác dụng phụ không mong muốn khi hàm lượng Clo trong nước máy vượt quá mức cho phép. Trong bài viết này, hãy cùng Coway Vina tìm hiểu một số cách khử Clo trong nước hiệu quả.

Nước Clo là gì?
Nước Clo là một loại nước chứa hàm lượng Clo (Cl2) hoặc các dạng hợp chất Clo khác nhau, được sử dụng để diệt khuẩn và tác nhân gây bệnh trong nước. Clo là một chất kháng khuẩn mạnh mẽ, có khả năng tiêu diệt các vi khuẩn, vi rút, và các tác nhân gây bệnh khác, làm cho nước trở nên an toàn và hợp vệ sinh để sử dụng trong các hoạt động hàng ngày như uống, nấu ăn và vệ sinh cá nhân.
Tuy nhiên, việc sử dụng Clo cần phải tuân thủ đúng liều lượng và kiểm soát hàm lượng Clo trong nước máy để đảm bảo an toàn cho sức khỏe của người sử dụng.
Nước Clo là nước có chứa Clo, giúp kháng khuẩn hiệu quả
Tác dụng và hàm lượng Clo trong nước máy được cho phép
Clo là một chất diệt khuẩn mạnh mẽ và có tác dụng tiêu diệt các vi khuẩn, vi rút, và các tác nhân gây bệnh trong nước. Do đó, việc sử dụng Clo trong quá trình xử lý nước máy là rất quan trọng để đảm bảo nước uống an toàn và đáng tin cậy.
Một số tác dụng khi khử Clo trong nước máy:
- Diệt khuẩn và vi khuẩn: Clo có khả năng tiêu diệt nhiều loại vi khuẩn và vi rút gây bệnh, bao gồm E. coli, Salmonella và Giardia. Nhờ vào tác dụng diệt khuẩn mạnh mẽ này, Clo giúp ngăn ngừa các bệnh truyền nhiễm do nước gây ra.
- Loại bỏ các tác nhân gây bệnh: Ngoài vi khuẩn, Clo cũng có khả năng loại bỏ các tác nhân gây bệnh khác như các loại tảo và nấm trong nước. Điều này đảm bảo rằng nước uống được làm sạch và an toàn cho sức khỏe.
- Phòng ngừa các bệnh truyền nhiễm: Sử dụng Clo trong nước máy giúp phòng ngừa các bệnh truyền nhiễm, tiêu chảy, sốt phát ban và nhiễm trùng đường ruột.
Hàm lượng Clo được cho phép trong nước máy:
Hàm lượng Clo trong nước máy được kiểm soát cẩn thận để đảm bảo an toàn sử dụng. Theo Tiêu chuẩn về nước uống của Tổ chức Y tế Thế giới (WHO), mức hàm lượng Clo trong nước nên nằm trong khoảng 0,2-2,0 mg/lít. Khi hàm lượng Clo trong nước máy nằm trong khoảng này, nước sẽ có tác dụng diệt khuẩn hiệu quả mà không gây hại đến sức khỏe con người.

Để đảm bảo an toàn, hàm lượng Clo trong nước nên là 0,2-2,0 mg/lít
Tuy nhiên, nếu hàm lượng Clo vượt quá mức cho phép, nước sẽ có mùi và vị Clo quá mạnh, gây khó chịu khi uống và có thể gây ra tác dụng phụ đối với sức khỏe. Để ngăn ngừa tác dụng phụ không mong muốn, bạn có thể tham khảo một số cách khử Clo trong nước được đề cập dưới đây.
Tác dụng phụ khi sử dụng nguồn nước chứa Clo không chuẩn
Sử dụng nguồn nước chứa Clo không chuẩn có thể gây ra một số tác dụng phụ không mong muốn đối với sức khỏe. Nếu nước chứa hàm lượng Clo quá cao, người dùng có thể cảm nhận mùi và vị Clo trong nước uống, gây khó chịu và không ngon miệng. Ngoài ra, sử dụng nước chứa Clo không đúng cách cũng có thể gây kích ứng da, tiêu chảy và khó tiêu sau khi uống nước.

Sử dụng nước Clo không đúng cách có thể gây kích ứng da và ngứa
Cách nhận biết nước máy dư Clo
Trước khi tìm hiểu về những phương pháp khử Clo trong nước, bạn cần quan tâm dấu hiệu cho thấy nguồn nước nhiễm Clo. Cách nhận Để nhận biết xem nước máy có Clo dư hay không, có một số phương pháp đơn giản mà bạn có thể áp dụng:
- Sử dụng bộ kiểm tra Clo nhanh: Đây là một công cụ đơn giản giúp xác định hàm lượng Clo có mặt trong nước. Bạn chỉ cần thả một số giọt dung dịch kiểm tra vào nước và quan sát kết quả. Nếu nước chứa Clo dư, kết quả kiểm tra sẽ cho thấy màu hoặc biểu tượng tương ứng.
- Quan sát mùi và màu nước: Nước có m��i Clo và có thể có màu vàng nhạt khi chứa hàm lượng Clo cao. Nếu bạn nhận thấy mùi hoặc màu nước không bình thường, có thể nước đang chứa Clo dư.

Nước bị dư Clo sẽ thường có màu vàng nhạt và mùi hôi khó chịu
Cách khử mùi Clo trong nước máy hiệu quả
Nước Clo mang lại một số lợi ích diệt khuẩn cho đời sống sinh hoạt nhưng cũng khiến nhiều người cảm thấy phiền phức, khó chịu. Dưới đây là một số cách khử Clo trong nước máy mà bạn có thể tham khảo áp dụng.
Đun sôi
Cách khử Clo trong nước đơn giản nhất chính là đun sôi. Đun sôi nước trong một khoảng thời gian ngắn sẽ giúp bay hơi Clo và loại bỏ mùi hôi. Bạn chỉ cần đun sôi nước trong khoảng 15-20 phút và sau đó để nước nguội tự nhiên trước khi sử dụng.
Sử dụng bộ lọc than hoạt tính
Phương pháp khử Clo trong nước thứ 2 này cũng được dùng khá phổ biến. Người ta dùng bộ lọc than hoạt tính để khử Clo và các chất hữu cơ khác trong nước. Bộ lọc này giúp hấp thụ các hợp chất Clo và các hợp chất gây mùi, giữ cho nước uống trong lành và tươi ngon hơn.
Sử dụng máy lọc nước có màng lọc RO
Máy lọc nước sử dụng công nghệ RO (REVERSE OSMOSIS) cũng có khả năng loại bỏ Clo và các chất ô nhiễm khác từ nguồn nước. RO là một phương pháp hiệu quả và an toàn để làm sạch nước uống. Trong quá trình lọc nước bằng RO, Clo và các hợp chất không mong muốn khác sẽ bị loại bỏ, để lại nước trong lành và không có mùi hôi Clo.

Máy lọc nước Coway Vina NADI (R) được thiết kế trang nhã
Tại Coway Vina, chúng tôi chuyên cung cấp cho khách hàng những dòng máy lọc RO hiện đại. Không chỉ giúp khử Clo trong nước, các dòng máy lọc nước Coway còn có khả năng loại bỏ các chất gây ô nhiễm nước như kim loại nặng, vi sinh vật, hóa chất hữu cơ có hại, v.v… đảm bảo đem lại cho gia đình bạn nguồn nước sạch, an toàn.
Phương pháp thoát khí
Thoát khí là một phương pháp khử mùi Clo nước máy. Khi nước chứa Clo dư, có thể sử dụng các thiết bị thoát khí đơn giản để xử lý nước. Các thiết bị này giúp loại bỏ khí Clo và giảm mùi hôi một cách đáng kể.
Cách làm khá đơn giản, bạn chỉ cần đặt thùng rộng chứa nước có chứa Clo, để Clo bay hơi tự nhiên. Điểm hạn chế là phương pháp này khá tốn thời gian, thường cần ít nhất 24 giờ để đạt được hiệu quả.
Phương pháp thác nước
Thác nước là một phương pháp tự nhiên để khử Clo trong nước. Khi nước chảy qua thác, Clo có thể bị oxy hóa và bay hơi, giúp giảm mùi Clo trong nước. Sử dụng nước từ các nguồn nước chảy như suối hoặc thác cũng giúp đảm bảo nước uống trong lành và tự nhiên hơn.
Phương pháp sục khí Ozone
Sục khí Ozone là một phương pháp tiên tiến để khử Clo trong nước và tiêu diệt vi khuẩn. Nguyên lý của phương pháp này là dùng Ozone (O3) để oxi hóa Clo thành Clo đôi, khi tiếp xúc với nước, và từ đó loại bỏ mùi hôi Clo. Sục khí Ozone không chỉ giúp khử mùi Clo mà còn làm cho nước trở nên sạch hơn.

Chúng ta có thể khử mùi Clo nhờ phương pháp sục khí Ozone
Với những phương pháp đơn giản và hiệu quả như đun sôi, sử dụng bộ lọc than hoạt tính, máy lọc nước RO… bạn có thể dễ dàng khử Clo trong nước máy một cách an toàn. Chúng ta nên luôn chú ý kiểm tra hàm lượng Clo trong nước và áp dụng các biện pháp khử mùi Clo để đảm bảo nước uống luôn sạch sẽ và tinh khiết.
Bên cạnh đó, việc có một máy lọc thông minh trong gia đình sẽ giúp bạn loại bỏ mối quan ngại về nguồn nước. Nếu bạn cần hỗ trợ về các phương pháp lọc nước thông minh, vui lòng liên hệ Coway Vina qua số hotline 1800.556.892 để được các chuyên gia tư vấn một cách nhanh chóng.